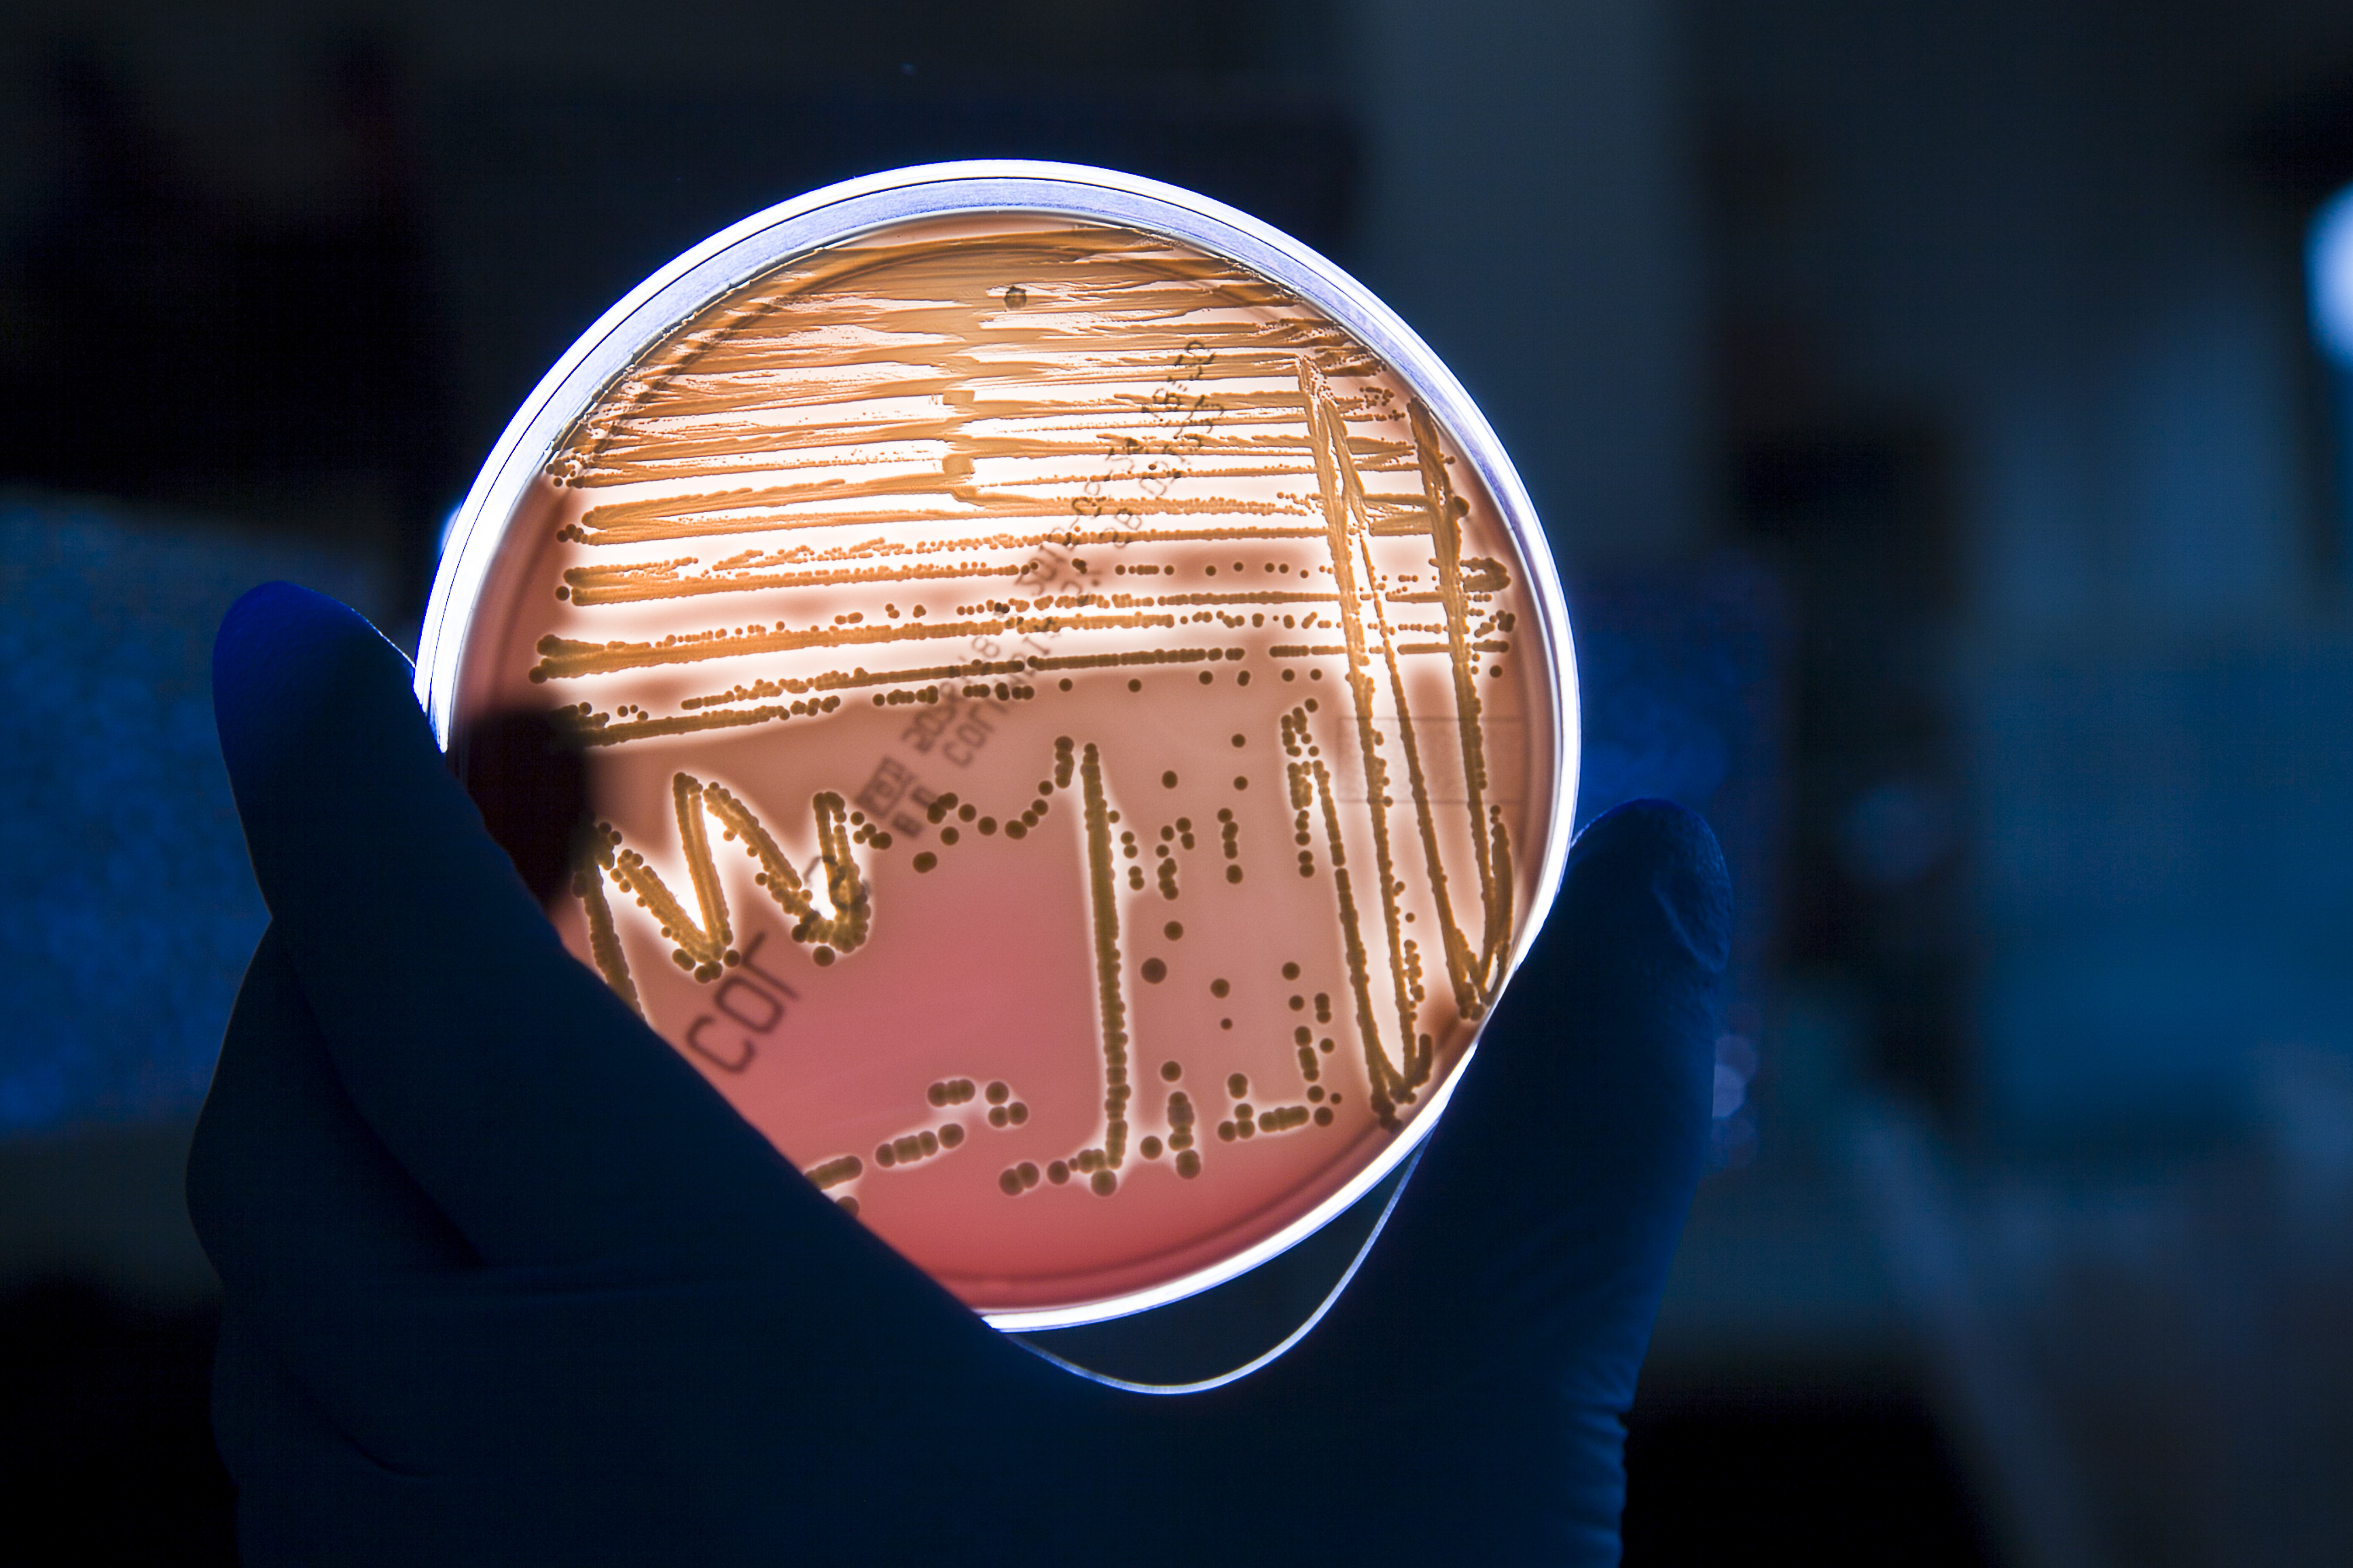
test di autovalutazione sui microrganismi negli alimenti

Notizie istituzionali
- icon-delibere

"Leggi bene, mangia meglio”, a Biella l’educazione alimentare sale in cattedra con l’IZSPLV
Un ciclo di incontri nelle scuole primarie di Borriana e Pralungo per insegnare ai bambini il valore delle etichette e la lotta allo spreco

IZSPLV, online i dati dell’attività scientifica 2025. Verso una piattaforma digitale per la consultazione interattiva
L’Istituto mette i suoi dati nella disponibilità dei cittadini

IL PRIMO CORSO DI FORMAZIONE IN SARDEGNA SULLA GESTIONE DEI CETACEI VIVI SPIAGGIATI
Centro Polivalente di Cabras - AMP del Sinis (OR) - 26-27 marzo 2026

RESILTROUT, il progetto PNRR che vede protagonista l’IZSPLV
Un progetto di filiera per rafforzare resilienza, sostenibilità e competitività della troticoltura Italiana

SPAZI IN TRASFORMAZIONE IN IZSPLV, ECCO LA NUOVA "PALAZZINA G”
C’erano una volta una stalla, un’officina e un magazzino. Al loro posto sorgerà un laboratorio chimico ipertecnologico

AUGURI DI SERENE FESTIVITÁ E DI UN FUTURO CHE CRESCE CON NOI
Rinnoviamo nel 2026 il nostro impegno, ogni giorno, insieme, costruendo sicurezza, conoscenza e progresso, ricercando e innovando al servizio della collettività.
Che il nuovo anno porti fiducia, armonie e nuove conquiste

FUNGHI, CI SIAMO! LA STAGIONE TANTO ATTESA DAGLI APPASSIONATI È ARRIVATA
Il controllo per la sicurezza nei consumi però viene prima di ogni cosa. Per questo l’IZSPLV organizza una prova comparativa per micologi iscritti al Registro nazionale

“SALUTE 6 ARTE”, AL LAVORO ANCHE MBAG
Giovedì 4 settembre 2025
Dopo "Dialoghi cromatici" di Mach 505 e Betty Amicucci, è inizia la realizzazione de "Il legame silenzioso" di Margherita Bobini e Andrea Gritti, in arte "MBAG"

ARTISTI AL LAVORO, SCATTA L'OPERAZIONE “SALUTE 6 ARTE”
Martedì 2 settembre 2025
"Dialoghi cromatici" di Mach 505 e Betty Amicucci è l'opera che dà il via alla realizzazione del progetto di riqualificazione urbana "Salute 6 Arte"

A ZINOLA UN ALTRO NIDO DI CARETTA CARETTA, IL QUARTO IN LIGURIA NEL 2025
Una tartaruga è stata vista deporre le uova sulla spiaggia libera del quartiere alla periferia ovest di Savona

L'EDUCATIVA ALIMENTARE INAUGURA IL PERCORSO SULL'INCLUSIONE SOCIALE
L'IZSLV ha tenuto il primo incontro nell'ambito della nuova Area del Banco Alimentare del Piemonte

Inclusione sociale, la partnership con il Banco Alimentare
A Moncalieri il 26 giugno - dalle 16 alle 18 - il primo percorso dedicato all’educativa alimentare

“SALUTE 6 ARTE”, SELEZIONATE LE OPERE
Sono tre i progetti di creatività urbana selezionati dalla Giuria. Ora sono al vaglio del Tavolo dell'Arte Urbana della Città di Torino e della Soprintendenza Archeologia Belle Arti e Paesaggio per la Città Metropolitana di Torino

Brucellosi e Bluetongue, l'impegno dell'IZSPLV
Nei primi cinque mesi dell'anno quintuplicati gli esami rispetto allo stesso periodo del 2024

“SALUTE 6 ARTE”, LA SCIENZA SI FA ARTE SUI MURI DELLA CITTÀ
Al via il bando dell’Istituto Zooprofilattico Sperimentale del Piemonte, Liguria e Valle d’Aosta per selezionare progetti di creatività urbana in via Bologna

SICUREZZA ALIMENTARE E SOSTENIBILITA' DEGLI ALLEVAMENTI
Sono stati i focus della missione dell'IZSPLV sulla cooperazione scientifica in Senegal

IZSPLV, APPROVATO DAL CDA IL BILANCIO PREVISIONALE 2025
Pareggerà a euro 42.176.378,44 in contrazione di euro 321.596,99 rispetto al 2024

FORUM RISK MANAGEMENT, LA VIA ITALIANA ALLA SALUTE PUBBLICA
Presentati ad Arezzo nel corso della rassegna “Forum risk management” i numeri e le attività della Rete degli Istituti Zooprofilattici Sperimentali Italiani

Scoperta scientifica sulla diagnosi precoce della Scrapie
La ricerca premiata al Convegno internazionale "Prion 2024" di Nanchang (Cina)

AD ARMA DI TAGGIA NUOVA NIFICAZIONE DI TARTARUGA IN LIGURIA
Dal 2021 è il quarto caso in cui viene scoperta una deposizione di uova da parte di una caretta caretta; è il secondo nel 2024

UN NIDO DI TARTARUGA MARINA CARETTA CARETTA A LAIGUEGLIA
Nella notte tra il 19 e il 20 giugno è stato osservato un esemplare che scavava sulla spiaggia una buca per deporre le uova.

APPROVATO IL PIANO PER LA STABILIZZAZIONE DEI RICERCATORI
Saranno assunti a tempo indeterminato diciannove tra Ricercatori e Collaboratori di supporto alla ricerca

Carcassa di Balenottera spiaggiata a Finale Ligure
Il CReDiMa eseguirà analisi genetiche e ricerca di inquinanti sugli organi e sul "blubber" del mammifero marino

Il Codice di Comportamento dell’IZSPLV è in aggiornamento
Eventuali osservazioni e proposte di modifiche al testo vanno presentate entro il 12 gennaio 2024

L'IZSPLV esplora nuovi orizzonti come partner di ELIXIR-IT
Annunciato l’ingresso dell'Istituto nel nodo italiano dell’infrastruttura europea per la bioinformatica

L’approccio “One Health”, occasione di confronto per la salvaguardia del pianeta
L’IZSPLV ha ospitato una delegazione dello “Zhejiang Provincial Center for Disease Control and Prevention”. Il Presidente dell’IZSPLV, Durando: «È stata l’occasione per lo sviluppo di nuove esperienze comuni».

Beccari e IZPLV, passioni e saperi condivisi
Nasce l’intesa per sviluppare una collaborazione virtuosa e innovativa, unendo con un mix creativo, esperienze ed entusiasmo giovanile

Alessandro Dondo è il nuovo Direttore sanitario dell'Istituto
L'incarico decorre dal 19 settembre 2023

ON LINE IL RAPPORTO PIEMONTESE "MTA 2022"
Il CeRTiS dell'IZSPLV ha collaborato alla redazione con i dati di sorveglianza e sierotipizzazione laboratoriale

INCONTRO TRA REGIONE AUTONOMA VALLE D'AOSTA E IZSPLV
La nuova sede valdostana dell’Istituto sarà a Chatillon

L’aumento della presenza di artropodi vettori
Il contributo dell’IZSPLV per la prevenzione delle patologie umane in ottica One Health

PRIMO SOCCORSO DI CETACEI SPIAGGIATI IN LIGURIA
Il primo passo verso la costituzione del "Gruppo di Pronto Intervento" è stato fatto a Imperia

LA SALA CONFERENZE INTITOLATA A CARLO ROSSI
Nei giorni scorsi si sono conclusi i lavori di adeguamento tecnologici e di allestimento della Sala conferenze dell’IZSPLV.

COSTA EDUTAINMENT E IZSPLV, SIGLATO ACCORDO PER LO SVILUPPO DI PROGETTI SCIENTIFICI
L’accordo è stato firmato presso l’Acquario di Genova dal Direttore Generale dell’IZSPLV, Angelo Ferrari, e dal Presidente di Costa Edutainment, Giuseppe Costa

L'Assessore Tresso in visita all'IZSPLV
L'Assessore della Città di Torino, Francesco Tresso, che ha tra le altre le deleghe alla Tutela degli animali, al Verde pubblico, e ai Parchi e alle Sponde fluviali, ha visitato i laboratori e le strutture dell'Istituto.
Durante l'incontro che ne è seguito, si sono poste le basi per una collaborazione per definire un protocollo d'intesa tra Città di Torino e Istituto.
Si è discusso su alcune criticità riguardanti l'igiene urbana, gli avvelenamenti di animali, e di specie alloctone che stanno invadendo parchi, corsi d'acqua e sponde fluviali della Città.


ONE HEALTH IN ONCOLOGIA, PRIMO INCONTRO A GENOVA
Dalla Regione Liguria un finanziamento di duecentomila euro per l’implementazione, l’integrazione e lo sviluppo dei registri tumori umani e animali

L’ACIDO CIANIDRICO CAUSA LA MORTE DEI 50 BOVINI. SALVATI 25 A SOMMARIVA, 5 A MORETTA, 6 A BRA
La sostanza tossica è presente naturalmente nella “durrina”, assunta dagli animali per ingestione da piante giovani di Sorgo

ISTITUITA COMMISSIONE SU UTILIZZO SPECIE ESOTICHE IN ACQUACOLUTRA
Tra i componenti Marino Prearo dell’IZSPLV

La sorveglianza delle Arbovirosi - Riscontrati due casi umani di West Nile Virus (WNV) in Piemonte
In allegato le regole per ridurre la proliferazione delle zanzare e per proteggersi dalle punture di insetti

La Regione Piemonte istituisce presso l’IZSPLV due nuovi Centri di Referenza
“Per la biodiversità degli ambienti acquatici" e
“Per la sorveglianza sulle patologie delle chiocciole, la salubrità dei prodotti alimentari derivati e la sostenibilità ambientale”

IZSPLV, PIOGGIA DI RICONOSCIMENTI AL SISVET
Premiato il lavoro sull’antimicrobico resistenza di ceppi di salmonella

Il premio “Best Presentation Award” dell’International Conference on Food Quality and Food Safety Management System in Food Science alle “nostre” Floris e Tramuta
Congratulazioni Irene, congratulazioni Clara!

ONE HEALTH, LA LOTTA AI TUMORI UMANI E ANIMALI
On line il questionario per sondare il livello di adesione al protocollo FNOVI – CEROVEC - LILT

RICERCA PSA, IN LIGURIA UN NUOVO LABORATORIO
Per la ricerca della Peste Suina Africana è stato attivato un laboratorio nella sede di Genova dell'Istituto Zooprofilattico Sperimentale del Piemonte, Liguria e Valle d'Aosta

L’IZSPLV assume personale nel ruolo della ricerca sanitaria. Le domande vanno presentate entro lunedì 4 aprile
Lunedì 4 aprile 2022 scadrà il termine per la partecipazione alla Selezione pubblica per l’assunzione di personale per le attività di ricerca presso l’Istituto Zooprofilattico Sperimentale del Piemonte, Liguria e Valle d’Aosta (IZSPLV).

La Peste Suina Africana, un’emergenza nazionale
Al workshop forniti dati e informazioni su attività e strategie per eradicare e contrastare la diffusione del virus

Il Sottosegretario Costa in visita all’IZSPLV
Questa mattina - lunedì 7 marzo 2022 - il sottosegretario di Stato al Ministero della Salute, Andrea Costa, ha visitato l'Istituto Zooprofilattico Sperimentale del Piemonte, Liguria e Valle d’Aosta.

I Centri di Referenza Nazionali dell’IZSLV
I nostri valori, le nostre attività, a tutela della salute

Partenogenesi di squalo Palombo comune
Primo caso documentato al mondo di riproduzione virginale
La conferma scientifica dell’IZSPLV

La Vespa velutina, una piaga per api e apicoltori
Progetto dell’IZSPLV per contrastarne la diffusione e salvaguardare biodiversità ed ecosistemi

"New pet in the city" è on line!
Hai o vorresti un animale esotico? Vuoi accudirlo al meglio e non sai come fare? "New pet in the city" è on line!

La Patologia Ittica Italiana premia i ricercatori dell’IZSPLV
Assegnato a Paolo Pastorino il “Pietro Ghittino" e riconoscimenti anche a Vasco Menconi e Davide Mugetti

Il Progetto SUPERTROUT è on line!
Da oggi, 28 ottobre 2021, all’url https://supertrout.izsplv.it è consultabile il sito internet del progetto SUPERTROUT.

IZSPLV, insediato il comitato etico: a presiederlo Massimo Gula
Si è insediato oggi, giovedì 21 ottobre 2021, il “Comitato Etico per la Sperimentazione animale” dell’Istituto Zooprofilattico Sperimentale del Piemonte Liguria e Valle d’Aosta.

È scomparso Antonino Romeo
È morto all’età di 94 anni, il dottor Antonino Romeo, già Presidente dell’Istituto Zooprofilattico Sperimentale del Piemonte, Liguria e Valle d’Aosta.

Squalo Palombo comune, primo caso di nascita senza fecondazione maschile
Attesa la conferma scientifica dalle analisi genetiche dell’IZSPLV

L’EFSA lancia la campagna di comunicazione #EUChooseSafeFood
L’impegno della scienza a garanzia del consumatore
Anche l’IZSPLV sostiene la campagna sulla sicurezza alimentare di EFSA

È mancato Gregorio Borsano
È scomparso ieri – 6 ottobre 2021, all’età di 89 anni, il dottor Gregorio Borsano, già Presidente dell’Istituto Zooprofilattico Sperimentale del Piemonte, Liguria e Valle d’Aosta.

Quello che vorresti sapere e non ha mai osato chiedere sul latte: On line il test di autovalutazione
IL NOSTRO TEAM A DISPOSIZIONE SUL TEMA SICUREZZA ALIMENTARE

Ocean to Ocean RIB Adventures 2021/2022
Ocean to Ocean RIB Adventures 2021/2022
Da Palermo a Los Angeles in gommone
IZSPLV partner scientifico

Ricerca e Innovazione per un’acquacoltura più sostenibile
L’Istituto Zooprofilattico Sperimentale del Piemonte, Liguria e Valle d’Aosta (IZSPLV), in collaborazione con l’Associazione Piscicoltori Italiani (API), ha organizzato il webinar “Ricerca e Innovazione per un’acquacoltura sostenibile”.

Delegazione Russa in visita per un audit all’IZSPLV
Nella mattina odierna l’Istituto Zooprofilattico Sperimentale del Piemonte, Liguria e Valle d'Aosta ha ospitato l’apertura dei lavori di un audit al quale partecipano le delegazioni del Ministero della Salute e della Federazione Russa.

WWW.IZSPLV.IT, SITO RINNOVATO E NUOVO DOMINIO DELL’IZSPLV
Da questa mattina è on line il nuovo sito web dell’Istituto Zooprofilattico Sperimentale del Piemonte, Liguria e Valle d’Aosta.

L'IZSPLV assumerà 80 ricercatori in sanità entro il 2021. Pubblicato il DPCM per procedere con i concorsi
L'IZSPLV assumerà 80 ricercatori in sanità entro il 2021

L’IZSPLV, Laboratorio di Riferimento per gli Stafilococchi dell'Irlanda del Nord
L’IZSPLV, Laboratorio di Riferimento per gli Stafilococchi dell'Irlanda del Nord
Erogherà servizi di supporto scientifico e di conferma analitica

Progetto per la creazione di un Centro studi sull'Elicicoltura
Progetto di collaborazione scientifica tra IZSPLV, Istituto Internazionale di Elicicoltura e Consorzio Chiocciola di Borgo e valli circostanti